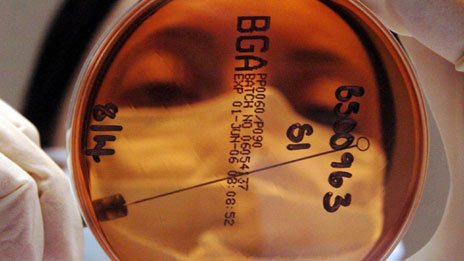

Ancient viruses 恐龍時期的病毒
Ancient viruses -- are they still with us?
媒體英語會帶大家一起學習 BBC 撰稿人在報道世界大事時常用到的單詞和短語。
一項研究結果顯示,遠在恐龍時代出現的一些病毒仍然在活躍于當代人類的遺傳基因里。
收聽與下載
至今為止,科學界對基因組的了解仍然處于初級狀態,科學家們希望這項研究能夠提供有關人類基因淵源的線索。BBC 記者 David Shukman 發回了以下報道。
With only a small part of our genetic material fully understood, scientists have been trying to unravel where most of our DNA came from and what it does. Now researchers from Oxford, New York and Belgium have investigated the genes of 38 mammals – including humans, mice, elephants and dolphins, and they've found that most of them share traces of the same ancient viruses. The work has established that at least one virus infected our common ancestors as long as one hundred million years ago.
The scientists found that these micro-organisms have adapted to stay within their host cell where they have thrived. So within the double helix of our DNA lies not only a legacy of past infections but also a miniature eco-system in which the viruses live on and evolve.
The researchers hope that further work will identify what role these genetic parasites might play. There's no evidence that they cause harm, indeed one ancient virus is known to help in the growth of the placenta. According to the senior author of the study, Dr Robert Belshaw of Oxford University, understanding these survivors from the distant past may provide clues to the early detection of cancers or infections.
Glossary 詞匯表 (點擊單詞收聽發音)
- to unravel解開
- genes基因
- traces微量的
- to establish確認
- micro-organism微生物
- to thrive繁榮興旺
- legacy遺留下來的資產
- parasites寄生蟲
- placenta胎盤
- to provide clues提供線索